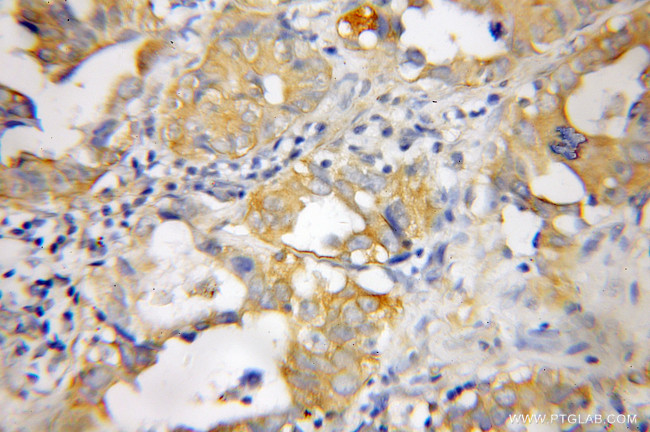
PTGDS Antibody in Immunohistochemistry (Paraffin) (IHC (P))
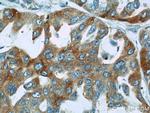
PTGDS Antibody in Immunohistochemistry (Paraffin) (IHC (P))

Search
Proteintech
PTGDS Polyclonal Antibody
{{$productOrderCtrl.translations['antibody.pdp.commerceCard.promotion.promotions']}}
{{$productOrderCtrl.translations['antibody.pdp.commerceCard.promotion.viewpromo']}}
{{$productOrderCtrl.translations['antibody.pdp.commerceCard.promotion.promocode']}}: {{promo.promoCode}} {{promo.promoTitle}} {{promo.promoDescription}}. {{$productOrderCtrl.translations['antibody.pdp.commerceCard.promotion.learnmore']}}
产品信息
10754-2-AP
种属反应
已发表种属
宿主/亚型
分类
类型
抗原
偶联物
形式
浓度
规格
纯化类型
保存液
内含物
保存条件
运输条件
产品详细信息
Immunogen sequence: MATHHTLWM GLALLGVLGD LQAAPEAQVS VQPNFQQDKF LGRWFSAGLA SNSSWLREKK AALSMCKSVV APATDGGLNL TSTFLRKNQC ETRTMLLQPA GSLGSYSYRS PHWGSTYSVS VVETDYDQYA LLYSQGSKGP GEDFRMATLY SRTQTPRAEL KEKFTAFCKA QGFTEDTIVF LPQTDKCMTE Q (1-190 aa encoded by BC005939)
靶标信息
The protein encoded by this gene is a glutathione-independent prostaglandin D synthase that catalyzes the conversion of prostaglandin H2 (PGH2) to postaglandin D2 (PGD2). PGD2 functions as a neuromodulator as well as a trophic factor in the central nervous system. PGD2 is also involved in smooth muscle contraction/relaxation and is a potent inhibitor of platelet aggregation. PTGDS has also been implicated in the development and maintenance of the blood-brain, blood-retina, blood-aqueous humor and blood-testis barrier. Studies with transgenic mice overexpressing this gene suggest that this gene may be also involved in the regulation of non-rapid eye movement (NREM) sleep. It is likely to play important roles in both maturation and maintenance of the central nervous system and male reproductive system. PTGDS is the most abundant protein in the cerebral spinal fluid and recent evidence suggests that PTGDS acts as a Beta-Amyloid chaperone and may have a role in the deposition of Ab plaques in Alzheimer's disease.
仅用于科研。不用于诊断过程。未经明确授权不得转售。
生物信息学
蛋白别名: Beta-trace protein; Cerebrin-28; Glutathione-independent PGD synthase; glutathione-independent PGD synthetase; L-PGDS; lipocalin-type prostaglandin D synthase; Lipocalin-type prostaglandin-D synthase; PGD2 synthase; prostaglandin D synthase; prostaglandin D2 synthase (21 kDa, brain); prostaglandin D2 synthase 21kDa (brain); Prostaglandin-D2 synthase; Prostaglandin-H2 D-isomerase; testis tissue sperm-binding protein Li 63n; unnamed protein product
基因别名: 21kDa; L-PGDS; LPGDS; PDS; PGD2; PGDS; PGDS2; PTGDS; Ptgs3
UniProt ID: (Human) P41222, (Mouse) O09114
Entrez Gene ID: (Human) 5730, (Mouse) 19215